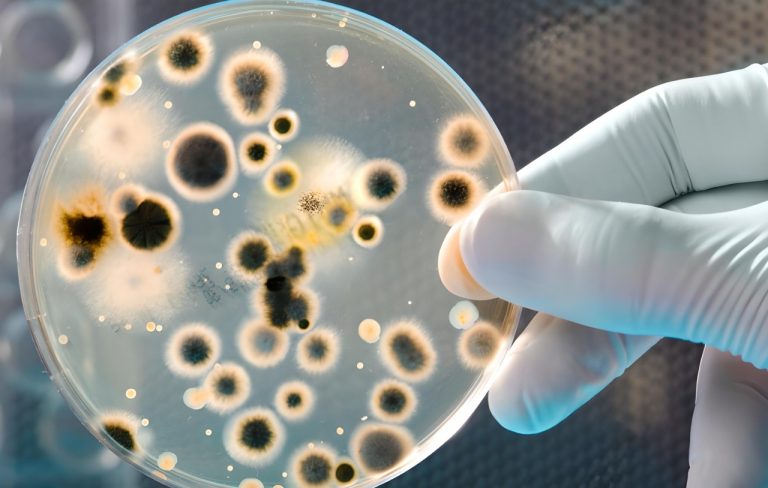

Impregnante biodegradable ofrece mayor duración y resistencia para la madera gracias a la lignina
Entrevista a Galo Cardenas
El investigador Galo Cárdenas, de la Universidad del Bío-Bío, desarrolló un preservante a base de lignina y sílice, con propiedades biocidas, ignífugas y anti UV, presentándose como un producto que pretende mejorar el desempeño de la madera en el uso exterior.
Desde la Revolución Industrial que el progreso se caracterizó por el desarrollo de productos y combustibles basados en el uso de carbón, el gas y el petróleo. Importantes avances de la humanidad, pero con consecuencias que traspasaron los libros y que hoy las vemos a nuestro alrededor. Tanto la extracción, el tratamiento y el consumo de este elemento pueden contaminar el aire, generando gases de efecto invernadero que favorecen el cambio climático, al igual que el agua y la Tierra, mediante fugas y fracturas del terreno. Frente a este panorama, la biomasa se presenta como una de las soluciones asequibles para reducir, en cierta medida, nuestra dependencia a los hidrocarburos.
En ese sentido, el desarrollo de bioproductos y biomateriales desde el sector maderero se obtiene desde las denominadas “plataformas químicas”, originadas a partir de tres principales biopolímeros que encontramos en los materiales lignocelulósicos; lignina, celulosa y hemicelulosa. Con respecto a la primera, es uno de los biopolímeros más abundantes en las plantas vasculares, y al igual que muchos otros componentes naturales, se forma mediante la reacción de fotosíntesis. Es así como se la considera un recurso renovable, asequible y de potencial uso industrial.
Fuente: Madera 21
El investigador Galo Cárdenas, de la Universidad del Bío-Bío, desarrolló un preservante a base de lignina y sílice, con propiedades biocidas, ignífugas y anti UV, presentándose como un producto que pretende mejorar el desempeño de la madera en el uso exterior.
Desde la Revolución Industrial que el progreso se caracterizó por el desarrollo de productos y combustibles basados en el uso de carbón, el gas y el petróleo. Importantes avances de la humanidad, pero con consecuencias que traspasaron los libros y que hoy las vemos a nuestro alrededor. Tanto la extracción, el tratamiento y el consumo de este elemento pueden contaminar el aire, generando gases de efecto invernadero que favorecen el cambio climático, al igual que el agua y la Tierra, mediante fugas y fracturas del terreno. Frente a este panorama, la biomasa se presenta como una de las soluciones asequibles para reducir, en cierta medida, nuestra dependencia a los hidrocarburos.
En ese sentido, el desarrollo de bioproductos y biomateriales desde el sector maderero se obtiene desde las denominadas “plataformas químicas”, originadas a partir de tres principales biopolímeros que encontramos en los materiales lignocelulósicos; lignina, celulosa y hemicelulosa. Con respecto a la primera, es uno de los biopolímeros más abundantes en las plantas vasculares, y al igual que muchos otros componentes naturales, se forma mediante la reacción de fotosíntesis. Es así como se la considera un recurso renovable, asequible y de potencial uso industrial.

La lignina es uno de los biopolímeros más abundantes / Agencias
Lo anterior fue demostrado por el químico y Doctor, Galo Cárdenas Triviño. El académico de la Universidad del Bío-Bío, específicamente, del Departamento de Ingeniería Civil de la Madera y de la Escuela de Ingeniería Química, es el creador de un impregnante biodegradable para maderas, que contiene nanopartículas de sílice, boro y cobre, con propiedades fungicidas, insecticidas, acaricidas e ignífugas, al igual que alto desempeño físico-mecánico. Una apuesta que busca potenciar su uso en el sector agrícola y forestal.
Este proyecto, financiado por el Fondo de Fomento al Desarrollo Científico y Tecnológico (Fondef), y en colaboración con el Ministerio de Vivienda y Urbanismo de Chile y el Instituto de Desarrollo Agropecuario, otorga mayor duración a las casas de maderas, ya sean de zonas urbanas como de áreas rurales, como también a las bodegas de almacenaje de semillas y frutos.
“Los polímeros o macromoléculas las tenemos en nuestra vida cotidiana y por ello siempre me ha interesado trabajar con celulosa, lignina, quitina y polisacáridos porque son naturales, renovables y biodegradables”, dijo anteriormente en una entrevista.
Sobre la investigación
Cárdenas fue Presidente de la Sociedad Chilena de Química, desde el 2001 hasta el 2006, también desempeñándose como Jefe del Área Polímeros Funcionales en CIPA, desde el año 2003 hasta 2010. Por otro lado, su carrera académica contempla más de 175 publicaciones científicas, ocho patentes nacionales e internacionales, junto con cerca de 380 presentaciones en congresos de América Latina, el Caribe y Europa. Y actualmente, es el Jefe del área de Bioproductos del Centro Nacional de Excelencia para la Industria de la Madera (CENAMAD). Experiencia que puso a disposición en esta investigación que comenzó en 2017.
Y es que este producto es un polímero natural, con nanopartículas de cobre, boro, sílice y lignina en porcentajes pequeños, que es amigable con el medio ambiente al mismo tiempo que mantiene las propiedades fungicidas y el control de termitas en la madera. Todo ello, a través de la composición de la lignina, específicamente por los polifenoles.
Junto con lo anterior, este producto fomenta propiedades anti-UV en el material y se diferencia de los ejemplares con CCA al no ser tóxicos. Cárdenas afirma que este material desarrollado es valioso y ha de incrementarse en el mercado chileno. Su producto ya dio el primer paso, que fue ser patentado, y este año, junto a su equipo, tendrán ensayos a escala piloto.
El académico, cuyas líneas de investigación son los biomateriales, nanomateriales, biomedicina, nanocompositos y los impregnantes de madera, ha dedicado su carrera al desarrollo de productos con aplicaciones industriales. Un ejemplo de ésto fueron las pinturas no contaminantes para redes de salmones.
El proyecto fue financiado por el Fondef, en colaboración con el Minvu y el Instituto de Desarrollo Agropecuario / Agencias
Y como fundador de la empresa Quitoquímica, dedicada a producir fertilizantes y nutrientes para la agricultura orgánica, él trabaja con el quitosano. Un biopolímero que se extrae del caparazón de los crustáceos. También, ha producido un spray comestible para proteger las frutas de hongos, levaduras e insectos en packings de exportación, y recientemente ha desarrollado el gel de quitosano con nanopartículas de plata y cobre para tratamiento de pie diabético.
“Me parece que, si queremos llegar a ser un país desarrollado en los próximos años, debemos ser capaz de innovar y crear tecnología propia en algunas áreas donde tenemos gran cantidad de materias primas, como son la minería y el desarrollo forestal. En esto último es donde la madera dimensionada de calidad y otros productos como tableros y enchapados permitirán incentivar la construcción de viviendas en madera, ya que en Chile se construye muy poco con madera, en comparación con el hemisferio norte, por ejemplo”, manifestó en la entrevista anteriormente citada.
La imperante y urgente crisis climática en la que se encuentra la humanidad exige, según diversos expertos, disminuir la dependencia de los combustibles fósiles y reducir drásticamente las emisiones de gases contaminantes que provocan el efecto invernadero. La producción de biocombustibles y bioproductos, a partir de la biomasa, es una estrategia que debe acompañarse de esfuerzos institucionales y colectivos. Y la lignina, junto a otros componentes en la naturaleza, son una fuente renovable y valiosa que pueden ser aprovechados de diversas maneras por la ciencia, la química y la academia. Como en este caso.